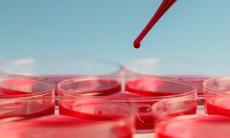
Policitemia: cauze, simptome, tratament

Articole medicale Medicina interna
Medicina interna
-
Anevrismul aortic abdominal
Anevrismul aortic abdominal este o dilatare patologica a aortei, cel mai mare vas arterial din corp. Desi poate reprezenta o urgenta medicala majora, anevrismul poate fi descoperit din timp si...
-
Cine prezinta risc de a dezvolta polipi biliari?
Vezica biliara este o structura anatomica de tip cavitar, este formata dintr-un perete sub forma de para in care este secretata si depozitata bila. Spre interiorul cavitatii acest perete poate...
-
Principalele metode de prevenire a durerilor de spate
Blocajele sau durerile de spate, in special la nivel lombar, reprezinta una dintre principalele cauze de dizabilitate in randul populatiei, este un motiv pentru care oamenii se prezinta frecvent la...
-
Splenomegalia sau marirea splinei - cauze, simptome, tratament
Splina, cunoscuta si ca „cimitirul globulelor rosii”, este cel mai mare organ limfoid din corpul uman avand rolul, asa cum ii spune si numele, de a capta si inlatura din sistem globulele rosii...
-
Tine colesterolul sub control!
Colesterolul este o substanta cu aspect cerat, asemanatoare grasimilor, produsa de ficat. Colesterolul apartine familiei lipidelor si este vital pentru formarea membranelor celulare, a anumitor...
-
Durerea in piept (durerea toracica anterioara) - cauze, simptome, tratament
Durerea, presiunea, incordarea sau discomfortul toracic constituie un indicator important in sistemul cardiac sau cardiovascular. Durerea toracica anterioara este unul dintre cele mai des intalnite...
-
Durere sub coaste in partea dreapta? Cand ar trebui sa te ingrijoreze durerea de ficat
Exista un reflex in a reclama dureri de ficat de fiecare data cand o persoana simte o anumita durere sub coasta, in partea dreapta. Desi, ficatul este situat in partea dreapta superioara a...
-
Ai mai multa grija de ficatul tau! Protejeaza-l cu solutii naturale
Ficatul este cel mai mare organ solid al organismului si indeplineste peste 500 de sarcini esentiale, totodata fiind si singurul organ care se poate regenera. Printre cele mai importante functii...
-
Mentine-ti ficatul sanatos!
Ficatul este cel mai mare organ solid si cea mai mare glanda din corpul uman, realizand peste 500 de sarcini esentiale. Acest organ este vital pentru functiile metabolice si sistemul imunitar al...
-
Nu lasa ficatul sa duca tot greul!
Ficatul, cel mai mare organ intern, este considerat un adevărat laborator al organismului, care prin multitudinea de roluri pe care le indeplineste asigura functionarea in parametri optimi a...
-
Efectele negative ale unei dureri netratate la timp
Durerea este o experienta senzoriala si emotionala neplacuta asociata unei agresiuni tisulare reale sau potentiale. Adesea, oamenii se raporteaza la durere doar ca la o senzatie fizica pe care vor...
-
Protejeaza-ti ficatul cu remedii naturale!
Ficatul- remarcabilul organ cu proprietati de regenerare si de reintinerire a celulelor distruse de o anumita boala sau o leziune. Ficatul realizeaza multiple sarcini esentiale, dintre care...
-
Ingrijeste-ti ficatul in mod natural
Ficatul este responsabil pentru cele mai importante procese din organism, fiind cel mai mare organ din corp. Ajuta la digestia mancarii si convertirea acesteia in energie, la eliminarea toxinelor...
-
Ai urmat un tratament medicamentos? Ficatul are urgent nevoie de protectie si regenerare!
Una dintre principalele functii ale ficatului este de a metaboliza substantele pe care le administram, inclusiv medicamente care ne ajuta sa vindecam alte afectiuni. Atunci cand medicamente noi...
-
Policitemia: cauze, simptome, tratament
Policitemia este o afectiune ce se refera la o crestere a numarului de globule rosii din organism. Numarul exagerat de celule suplimentare va face ca sangele sa aiba o densitate mai mare si sa se...
Specialitati medicale
- Alergologie-Imunologie
- Analize medicale
- Cardiologie
- Chirurgie generala
- Chirurgie plastica
- Dermatologie-Estetica
- Diabet, nutritie, boli metabolice
- Diete-Nutritie
- Endocrinologie
- Flebologie
- Gastroenterologie
- Ginecologie
- Hematologie
- Homeopatie
- Imagistica Medicala
- Infectioase
- Medicina alternativa
- Medicina Generala
- Medicina interna
- Nefrologie
- Neurologie
- Oftalmologie
- Oncologie
- ORL
- Ortopedie
- Pediatrie
- Pneumofiziologie
- Proctologie
- Psihologie-Psihiatrie
- Recuperare medicala
- Reumatologie
- Sanatate sport
- Sarcina
- Sexologie
- Stomatologie
- Urologie
-
Interpretare simptome
semnificatia simptomelor si afectiunile probabile
Afla acum

Urmareste Sfatul Medicului
Aboneaza-te la Newsletter